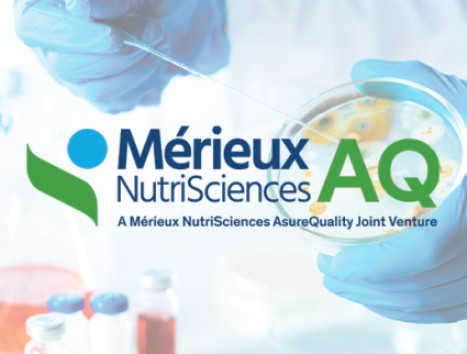
Merieux AQ 630x400

News
Explore industry insights and stay informed on the latest in food safety, sustainability, and quality assurance.
Filter News

Innovation really counts when it works on the plant floor
AsureQuality is transforming meat inspection with AI-assisted carcass analysis, boosting food safety, efficiency, and traceability for global markets....
New People Hub at AsureQuality Lynfield Site Marks Major Step for NZ Food Industry
AsureQuality opens new People Hub at Lynfield, boosting lab capacity, innovation, and collaboration to support NZ’s $70b food industry.
...
Helping you compete globally for 150 years
For 150 years, AsureQuality has helped make that possible through our independent food assurance services. ...
AsureQuality re-appointed NZGAP assurance partner
We are pleased to have been re-appointed to continue providing auditing services for all New Zealand Good Agricultural Practice (NZGAP) programmes, extending As...

Supporting the meat processing industry with cloth swab sampling for E. coli Top 7 STEC testing
AsureQuality offers NZ’s first IANZ-accredited cloth swab E. coli testing — faster, safer, cost-effective sampling to help meat processors meet NMD compliance....
Mérieux NutriSciences and AsureQuality Announce the Official Launch of Mérieux NutriSciences AQ (MNAQ) Joint Venture
Mérieux NutriSciences and AsureQuality Announce the Official Launch of Mérieux NutriSciences AQ (MNAQ) Joint Venture...

AsureQuality hosts breakfast with global food safety expert, Frank Yiannas
AsureQuality hosted breakfast with food safety expert Frank Yiannas, sharing insights on building strong food safety culture and leadership in NZ’s food sector....

Furthering laboratory cooperation between Sri Lanka and New Zealand
AsureQuality welcomed a Sri Lanka Standards Institution (SLSI) delegation to our Auckland Lab, advancing NZ-Sri Lanka ties in food safety and lab cooperation....

AsureQuality Academy launches Food Safety Governance training
AsureQuality Academy, with the Institute of Directors & NZ Food Safety, offers CPD-accredited half-day training for food industry CEOs & directors...

Sustainable farm lending programmes
AsureQuality works with our banking partners to provide assurance services for sustainable lending programmes....